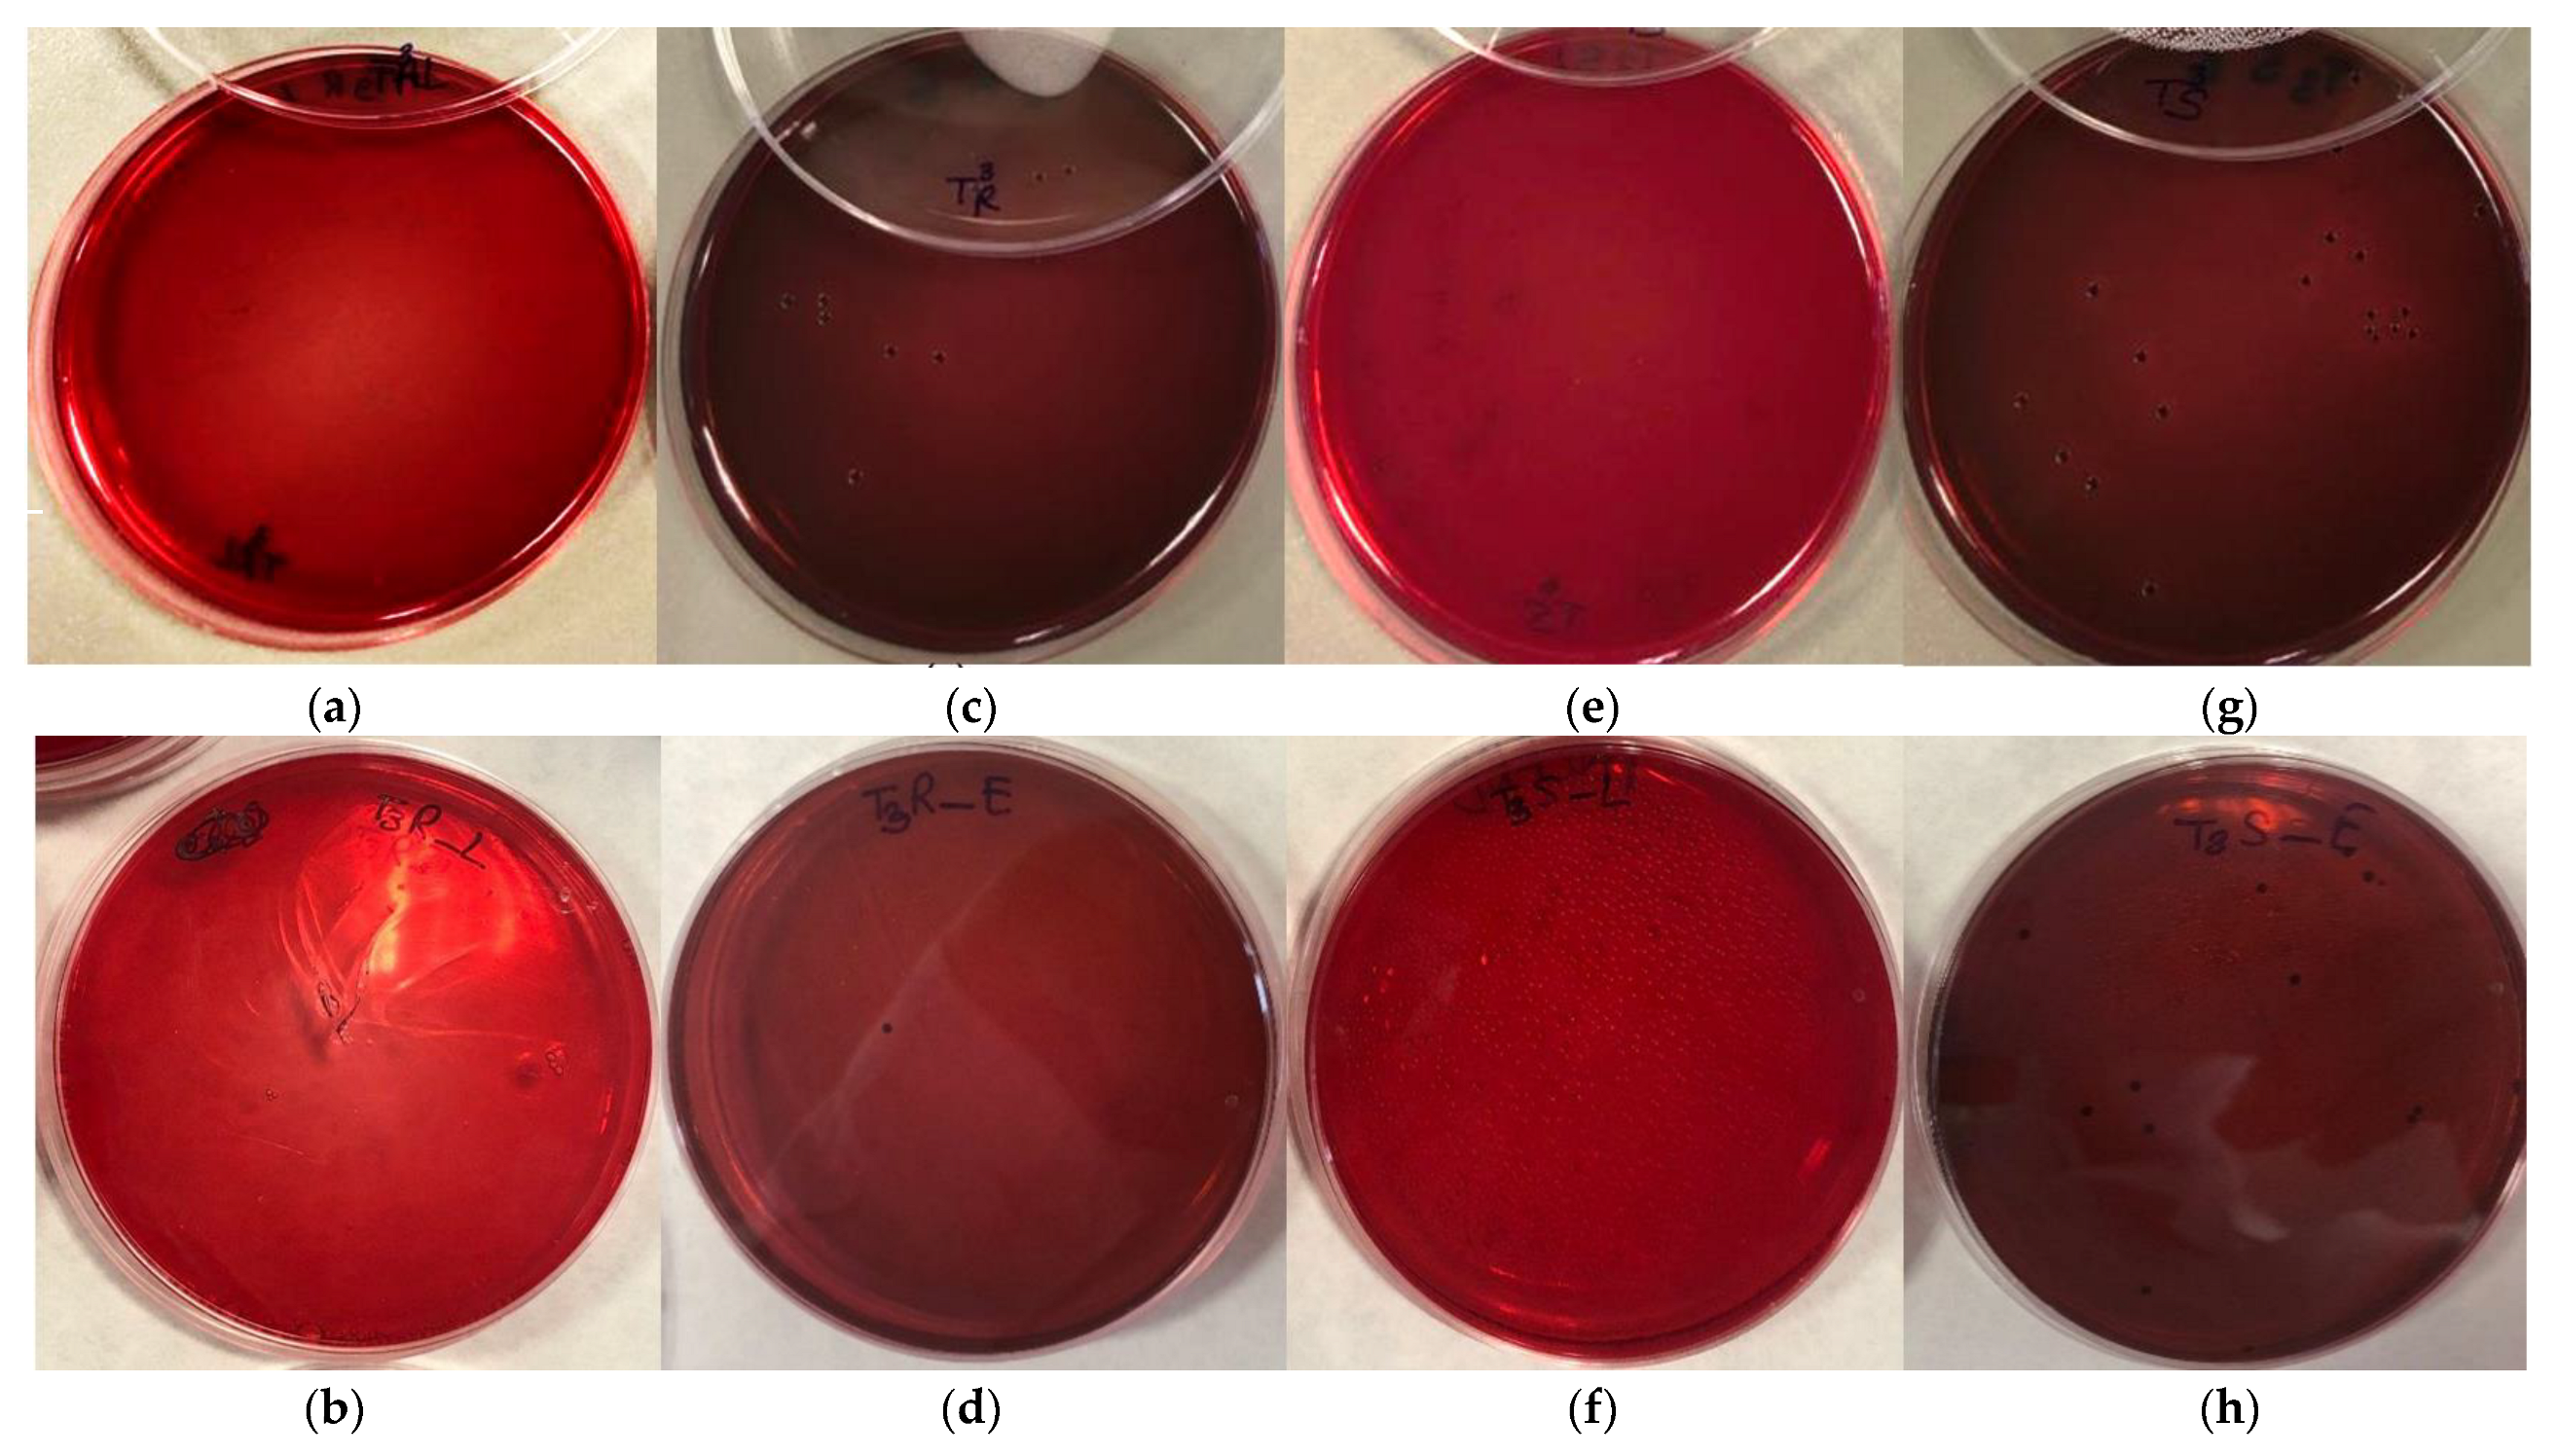
Bioengineering 10 00297 g006 Bioengineering 10 00297 g006
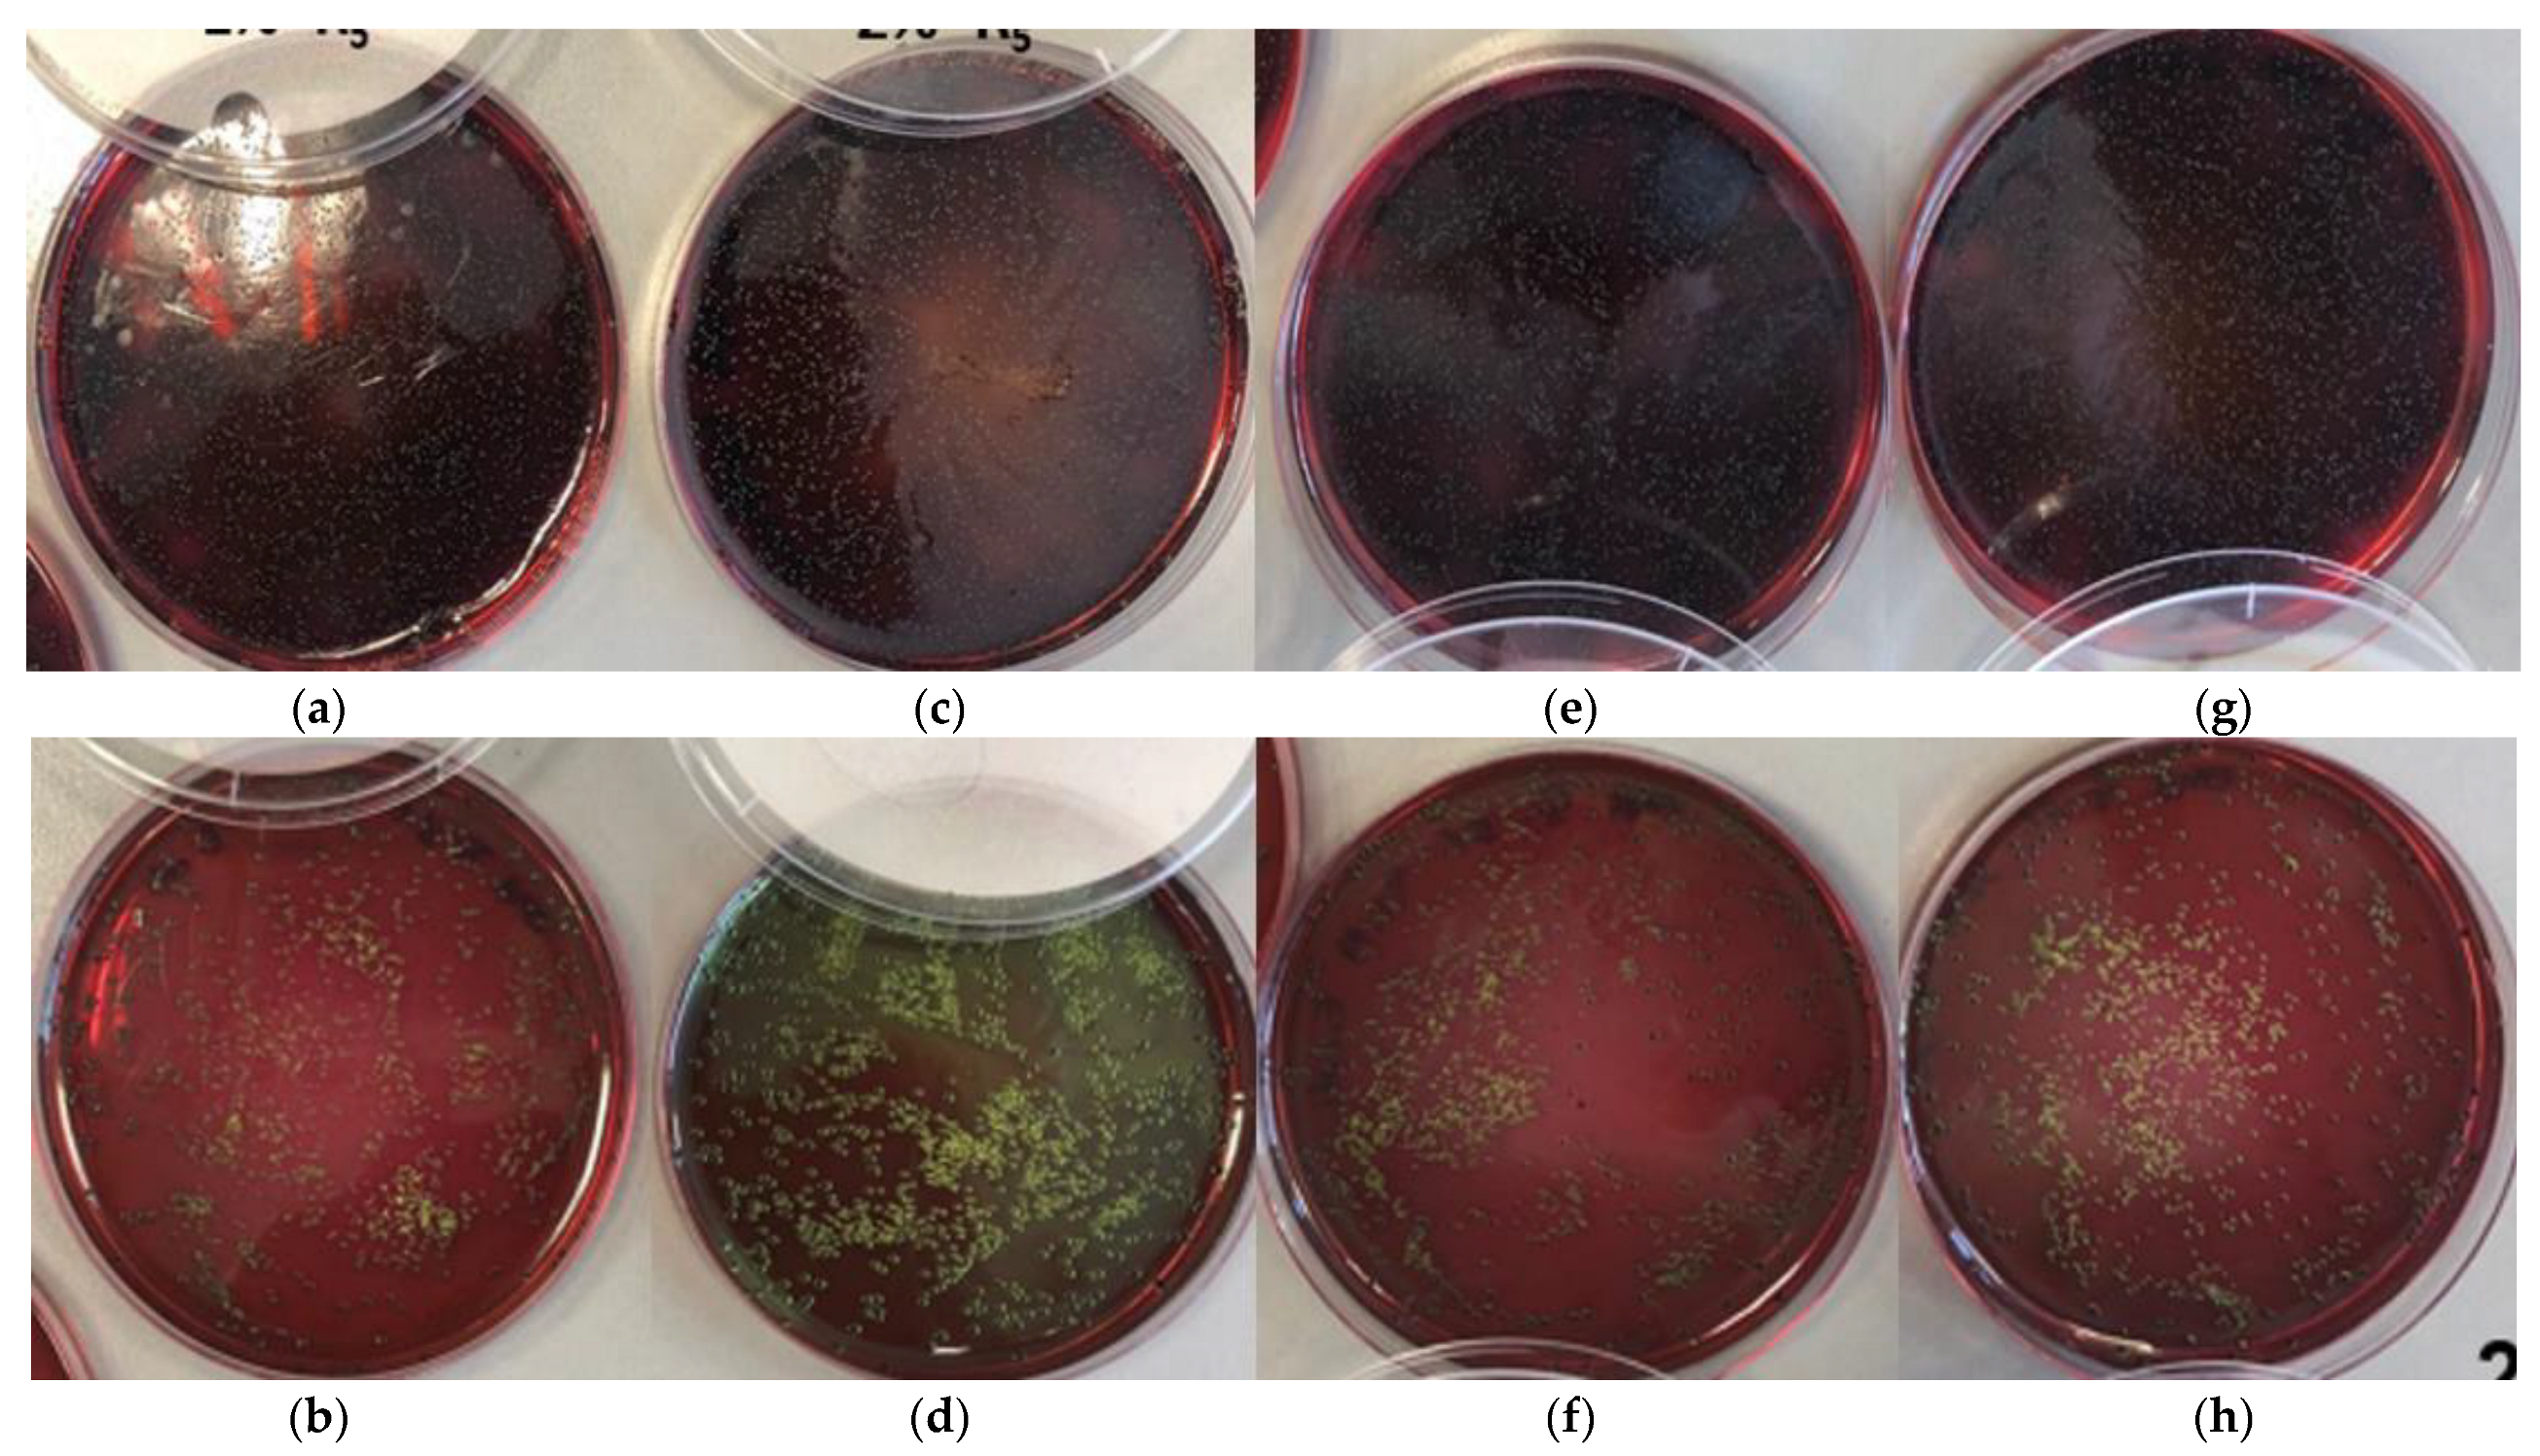
Bioengineering 10 00297 g007 Bioengineering 10 00297 g007

Preliminary Study of the Bactericide Properties of Biodegradable Polymers (PLA) with Metal Additives for 3D Printing Applications
Abstract
1. Introduction
2. Materials and Methods
2.1. Polymer, Additives and Bacteria
2.2. Preparation of PLA and Silver Additives Compounds
2.3. Bacterial Growth Conditions
2.4. Microscopy
2.5. Particle Size
2.6. FTIR Spectroscopy
2.7. Evaluation of Bacterial Activity in Powder
2.8. Evaluation of Bacterial Activity in Compound
2.9. Evaluation of Bacterial Activity in 3D-Printed Parts
3. Results and Discussion
3.1. Microscopy
3.2. Particle Size
3.3. FTIR Spectroscopy
3.4. Bacterial Activity in Powder
3.5. Bacterial Activity in Compound
3.6. Bacterial Activity in 3D Printing
4. Conclusions
Author Contributions
Funding
Institutional Review Board Statement
Informed Consent Statement
Data Availability Statement
Acknowledgments
Conflicts of Interest
References
- Roberts, C.A.; Buikstra, J.E. Bacterial Infections; Elsevier Inc.: Amsterdam, The Netherlands, 2019. [Google Scholar] [CrossRef]
- Roca, I.; Akova, M.; Baquero, F.; Carlet, J.; Cavaleri, M.; Coenen, S.; Cohen, J.; Findlay, D.; Gyssens, I.; Heure, O.E.; et al. The Global Threat of Antimicrobial Resistance: Science for Intervention. New Microbes New Infect. 2015, 6, 22–29. [Google Scholar] [CrossRef] [PubMed]
- Fujiyoshi, S.; Tanaka, D.; Maruyama, F. Transmission of Airborne Bacteria across Built Environments and Its Measurement Standards: A Review. Front. Microbiol. 2017, 8, 2336. [Google Scholar] [CrossRef] [PubMed]
- Ghosh, S.; Mukherjee, R.; Basak, D.; Haldar, J. One-Step Curable, Covalently Immobilized Coating for Clinically Relevant Surfaces That Can Kill Bacteria, Fungi, and Influenza Virus. ACS Appl. Mater. Interfaces 2020, 12, 27853–27865. [Google Scholar] [CrossRef]
- Demchenko, V.; Kobylinskyi, S.; Iurzhenko, M.; Riabov, S.; Vashchuk, A.; Rybalchenko, N.; Zahorodnia, S.; Naumenko, K.; Demchenko, O.; Adamus, G.; et al. Nanocomposites Based on Polylactide and Silver Nanoparticles and Their Antimicrobial and Antiviral Applications. React. Funct. Polym. 2022, 170, 105096. [Google Scholar] [CrossRef]
- Pettinari, C.; Pettinari, R.; Di Nicola, C.; Tombesi, A.; Scuri, S.; Marchetti, F. Antimicrobial MOFs. Coord. Chem. Rev. 2021, 446, 214121. [Google Scholar] [CrossRef]
- Beisl, S.; Monteiro, S.; Santos, R.; Figueiredo, A.S.; Sánchez-Loredo, M.G.; Lemos, M.A.; Lemos, F.; Minhalma, M.; de Pinho, M.N. Synthesis and Bactericide Activity of Nanofiltration Composite Membranes—Cellulose Acetate/Silver Nanoparticles and Cellulose Acetate/Silver Ion Exchanged Zeolites. Water Res. 2019, 149, 225–231. [Google Scholar] [CrossRef]
- Liu, W.; Li, J.; Cheng, M.; Wang, Q.; Qian, Y.; Yeung, K.W.K.; Chu, P.K.; Zhang, X. A Surface-Engineered Polyetheretherketone Biomaterial Implant with Direct and Immunoregulatory Antibacterial Activity against Methicillin-Resistant Staphylococcus aureus. Biomaterials 2019, 208, 8–20. [Google Scholar] [CrossRef]
- Chen, X.; Nie, Q.; Shao, Y.; Wang, Z.; Cai, Z. TiO2 Nanoparticles Functionalized Borneol-Based Polymer Films with Enhanced Photocatalytic and Antibacterial Performances. Environ. Technol. Innov. 2021, 21, 101304. [Google Scholar] [CrossRef]
- González-Ceballos, L.; Guirado-moreno, J.C.; Guembe-García, M.; Rovira, J.; Melero, B.; Arnaiz, A.; Diez, A.M.; García, J.M.; Vallejos, S. Metal-Free Organic Polymer for the Preparation of a Reusable Antimicrobial Material with Real-Life Application as an Absorbent Food Pad. Food Packag. Shelf Life 2022, 33, 100910. [Google Scholar] [CrossRef]
- Rogalsky, S.; Bardeau, J.F.; Lyoshina, L.; Tarasyuk, O.; Bulko, O.; Dzhuzha, O.; Cherniavska, T.; Kremenitsky, V.; Kobrina, L.; Riabov, S. New Promising Antimicrobial Material Based on Thermoplastic Polyurethane Modified with Polymeric Biocide Polyhexamethylene Guanidine Hydrochloride. Mater. Chem. Phys. 2021, 267, 124682. [Google Scholar] [CrossRef]
- Ding, H.H.; Zhao, M.H.; Zhai, L.; Zhen, J.B.; Sun, L.Y.; Chigan, J.Z.; Chen, C.; Li, J.Q.; Gao, H.; Yang, K.W. A Quinine-Based Quaternized Polymer: A Potent Scaffold with Bactericidal Properties without Resistance. Polym. Chem. 2021, 12, 2397–2403. [Google Scholar] [CrossRef]
- Avcu, E.; Bastan, F.E.; Guney, M.; Yildiran Avcu, Y.; Ur Rehman, M.A.; Boccaccini, A.R. Biodegradable Polymer Matrix Composites Containing Graphene-Related Materials for Antibacterial Applications: A Critical Review. Acta Biomater. 2022, 151, 1–44. [Google Scholar] [CrossRef] [PubMed]
- Mural, P.K.S.; Banerjee, A.; Rana, M.S.; Shukla, A.; Padmanabhan, B.; Bhadra, S.; Madras, G.; Bose, S. Polyolefin Based Antibacterial Membranes Derived from PE/PEO Blends Compatibilized with Amine Terminated Graphene Oxide and Maleated PE. J. Mater. Chem. A 2014, 2, 17635–17648. [Google Scholar] [CrossRef]
- Domínguez-Robles, J.; Larrañeta, E.; Fong, M.L.; Martin, N.K.; Irwin, N.J.; Mutjé, P.; Tarrés, Q.; Delgado-Aguilar, M. Lignin/Poly(Butylene Succinate) Composites with Antioxidant and Antibacterial Properties for Potential Biomedical Applications. Int. J. Biol. Macromol. 2020, 145, 92–99. [Google Scholar] [CrossRef] [PubMed]
- Godoy-Gallardo, M.; Eckhard, U.; Delgado, L.M.; de Roo Puente, Y.J.D.; Hoyos-Nogués, M.; Gil, F.J.; Perez, R.A. Antibacterial Approaches in Tissue Engineering Using Metal Ions and Nanoparticles: From Mechanisms to Applications. Bioact. Mater. 2021, 6, 4470–4490. [Google Scholar] [CrossRef]
- Thomas, V.; Yallapu, M.M.; Sreedhar, B.; Bajpai, S.K. A Versatile Strategy to Fabricate Hydrogel-Silver Nanocomposites and Investigation of Their Antimicrobial Activity. J. Colloid Interface Sci. 2007, 315, 389–395. [Google Scholar] [CrossRef] [PubMed]
- Gowriboy, N.; Kalaivizhi, R.; Kaleekkal, N.J.; Ganesh, M.R.; Aswathy, K.A. Fabrication and Characterization of Polymer Nanocomposites Membrane (Cu-MOF@CA/PES) for Water Treatment. J. Environ. Chem. Eng. 2022, 10, 108668. [Google Scholar] [CrossRef]
- Hopta, O.V.; Mishyna, M.M.; Syrova, A.O.; Makarov, V.O.; Avramenko, V.L.; Mishurov, D.O. Evaluation of Antimicrobial Properties of Polymer Nanocomposites for Medical Application. Regul. Mech. Biosyst. 2019, 10, 484–488. [Google Scholar] [CrossRef]
- Chowdhury, P.; Roy, B.; Mukherjee, S.; Mukherjee, N.; Joardar, N.; Roy, D.; Chowdhury, S.; Babu, S.P.S. Polymer Anchored Gold Nanoparticles: Synthesis, Characterization and Antimicrobial Activities. Nanosci. Nanotechnol. Asia 2021, 11, 119–131. [Google Scholar] [CrossRef]
- Jayaramudu, T.; Raghavendra, G.M.; Varaprasad, K.; Sadiku, R.; Raju, K.M. Development of Novel Biodegradable Au Nanocomposite Hydrogels Based on Wheat: For Inactivation of Bacteria. Carbohydr. Polym. 2013, 92, 2193–2200. [Google Scholar] [CrossRef]
- Ciubotariu, A.C.; Benea, L.; Sand, W. Effects of Sulphate Reducing Bacteria on Thermosetting Polymers/Zn Composite Coatings. Sci. Bull. “Mircea Cel Batran” Nav. Acad. 2015, 18, 162. [Google Scholar]
- Kretsinger, R.H.; Uversky, V.N.; Permyakov, E.A. Encyclopedia of Metalloproteins, 1st ed.; Springer Science+Business Media: New York, NY, USA, 2013. [Google Scholar] [CrossRef]
- Cerrillo, J.L.; Palomares, A.E.; Rey, F. Silver Exchanged Zeolites as Bactericidal Additives in Polymeric Materials. Microporous Mesoporous Mater. 2020, 305, 110367. [Google Scholar] [CrossRef]
- Chu, H.Y.; Fu, H.; Liu, A.; Wang, P.; Cao, Y.L.; Du, A.F.; Wang, C.C. Two Silver-Based Coordination Polymers Constructed from Organic Carboxylate Acids and 4, 4′-Bipyridine-like Bidentate Ligands: Synthesis, Structure, and Antimicrobial Performances. Polyhedron 2020, 188, 114684. [Google Scholar] [CrossRef]
- Ratvijitvech, T.; Na Pombejra, S. Antibacterial Efficiency of Microporous Hypercrosslinked Polymer Conjugated with Biosynthesized Silver Nanoparticles from Aspergillus niger. Mater. Today Commun. 2021, 28, 102617. [Google Scholar] [CrossRef]
- Liu, X.; Gan, K.; Liu, H.; Song, X.; Chen, T.; Liu, C. Antibacterial Properties of Nano-Silver Coated PEEK Prepared through Magnetron Sputtering. Dent. Mater. 2017, 33, e348–e360. [Google Scholar] [CrossRef] [PubMed]
- Slavin, Y.N.; Asnis, J.; Häfeli, U.O.; Bach, H. Metal Nanoparticles: Understanding the Mechanisms behind Antibacterial Activity. J. Nanobiotechnol. 2017, 15, 65. [Google Scholar] [CrossRef]
- Kędziora, A.; Speruda, M.; Krzyżewska, E.; Rybka, J.; Łukowiak, A.; Bugla-Płoskońska, G. Similarities and Differences between Silver Ions and Silver in Nanoforms as Antibacterial Agents. Int. J. Mol. Sci. 2018, 19, 444. [Google Scholar] [CrossRef]
- Roy, A.; Bulut, O.; Some, S.; Mandal, A.K.; Yilmaz, M.D. Green Synthesis of Silver Nanoparticles: Biomolecule-Nanoparticle Organizations Targeting Antimicrobial Activity. RSC Adv. 2019, 9, 2673–2702. [Google Scholar] [CrossRef]
- Ramya, A.; Vanapalli, S.L. 3D Printing Technologies in Various Applications. Int. J. Mech. Eng. Technol. 2016, 7, 396–409. [Google Scholar]
- Chua, K.; Khan, I.; Malhotra, R.; Zhu, D. Additive Manufacturing and 3D Printing of Metallic Biomaterials. Eng. Regen. 2021, 2, 288–299. [Google Scholar] [CrossRef]
- Chen, Z.; Li, Z.; Li, J.; Liu, C.; Lao, C.; Fu, Y.; Liu, C.; Li, Y.; Wang, P.; He, Y. 3D Printing of Ceramics: A Review. J. Eur. Ceram. Soc. 2019, 39, 661–687. [Google Scholar] [CrossRef]
- Singh, S.; Ramakrishna, S.; Berto, F. 3D Printing of Polymer Composites: A Short Review. Mater. Des. Process. Commun. 2020, 2, e97. [Google Scholar] [CrossRef]
- Pagano, S.; Lombardo, G.; Caponi, S.; Costanzi, E.; Di Michele, A.; Bruscoli, S.; Xhimitiku, I.; Coniglio, M.; Valenti, C.; Mattarelli, M.; et al. Bio-Mechanical Characterization of a CAD/CAM PMMA Resin for Digital Removable Prostheses. Dent. Mater. 2021, 37, e118–e130. [Google Scholar] [CrossRef] [PubMed]
- Shahrubudin, N.; Lee, T.C.; Ramlan, R. An Overview on 3D Printing Technology: Technological, Materials, and Applications. Procedia Manuf. 2019, 35, 1286–1296. [Google Scholar] [CrossRef]
- Wang, Y.; Ahmed, A.; Azam, A.; Bing, D.; Shan, Z.; Zhang, Z.; Tariq, M.K.; Sultana, J.; Mushtaq, R.T.; Mehboob, A.; et al. Applications of Additive Manufacturing (AM) in Sustainable Energy Generation and Battle against COVID-19 Pandemic: The Knowledge Evolution of 3D Printing. J. Manuf. Syst. 2021, 60, 709–733. [Google Scholar] [CrossRef]
- Varghese, R.; Salvi, S.; Sood, P.; Karsiya, J.; Kumar, D. 3D Printed Medicine for the Management of Chronic Diseases: The Road Less Travelled. Ann. 3D Print. Med. 2022, 5, 100043. [Google Scholar] [CrossRef]
- Moazzam, M.; Shehzad, A.; Sultanova, D.; Mukasheva, F.; Trifonov, A.; Berillo, D.; Akilbekova, D. Macroporous 3D Printed Structures for Regenerative Medicine Applications. Bioprinting 2022, 28, e00254. [Google Scholar] [CrossRef]
- Quinzi, V.; Gallusi, G.; Carli, E.; Pepe, F.; Rastelli, E.; Tecco, S. Elastodontic Devices in Orthodontics: An In-Vitro Study on Mechanical Deformation under Loading. Bioengineering 2022, 9, 282. [Google Scholar] [CrossRef]
- Podstawczyk, D.; Skrzypczak, D.; Połomska, X.; Stargała, A.; Witek-Krowiak, A.; Guiseppi-Elie, A.; Galewski, Z. Preparation of Antimicrobial 3D Printing Filament: In Situ Thermal Formation of Silver Nanoparticles during the Material Extrusion. Polym. Compos. 2020, 41, 4692–4705. [Google Scholar] [CrossRef]
- Vidakis, N.; Petousis, M.; Velidakis, E.; Liebscher, M.; Tzounis, L. Three-Dimensional Printed Antimicrobial Objects of Polylactic Acid (PLA)-Silver Nanoparticle Nanocomposite Filaments Produced by an In-Situ Reduction Reactive Melt Mixing Process. Biomimetics 2020, 5, 42. [Google Scholar] [CrossRef]
- Tse, I.; Jay, A.; Na, I.; Murphy, S.; Niño-Martínez, N.; Martínez-Castañon, G.A.; Magrill, J.; Bach, H. Antimicrobial Activity of 3d-Printed Acrylonitrile Butadiene Styrene (Abs) Polymer-Coated with Silver Nanoparticles. Materials 2021, 14, 7681. [Google Scholar] [CrossRef] [PubMed]
- Sánchez-Salcedo, S.; García, A.; González-Jiménez, A.; Vallet-Regí, M. Antibacterial Effect of 3D Printed Mesoporous Bioactive Glass Scaffolds Doped with Metallic Silver Nanoparticles. Acta Biomater. 2022, 155, 654–666. [Google Scholar] [CrossRef] [PubMed]
- Maróti, P.; Kocsis, B.; Ferencz, A.; Nyitrai, M.; Lőrinczy, D. Differential Thermal Analysis of the Antibacterial Effect of PLA-Based Materials Planned for 3D Printing. J. Therm. Anal. Calorim. 2020, 139, 367–374. [Google Scholar] [CrossRef]
- Zhang, K.; Yu, H.O.; Yu, K.X.; Gao, Y.; Wang, M.; Li, J.; Guo, S. A Facile Approach to Constructing Efficiently Segregated Conductive Networks in Poly(Lactic Acid)/Silver Nanocomposites via Silver Plating on Microfibers for Electromagnetic Interference Shielding. Compos. Sci. Technol. 2018, 156, 136–143. [Google Scholar] [CrossRef]
- Εkonomou, S.; Soe, S.; Stratakos, A.C. An Explorative Study on the Antimicrobial Effects and Mechanical Properties of 3D Printed PLA and TPU Surfaces Loaded with Ag and Cu against Nosocomial and Foodborne Pathogens. J. Mech. Behav. Biomed. Mater. 2023, 137, 105536. [Google Scholar] [CrossRef] [PubMed]
- Fan, C.; Cui, R.; Lu, W.; Chen, H.; Yuan, M.; Qin, Y. Effect of High Pressure Treatment on Properties and Nano–Ag Migration of PLA-Based Food Packaging Film. Polym. Test. 2019, 76, 73–81. [Google Scholar] [CrossRef]
- UNE-EN ISO 11290-2; Método Horizontal Para La Detección y El Recuento de Listeria monocytogenes y de Listeria spp.—Parte 2: Método de Recuento. Organización Internacional de Normalización [ISO]: Geneva, Switzerland, 2018.
- UNE-EN ISO 21150; Detección de Escherichia coli. Organización Internacional de Normalización [ISO]: Geneva, Switzerland, 2020.
- UNE-EN ISO 11290-1; Método Horizontal Para La Deteccion y Recuento de Listeria monocytogenes y de Listeria spp.—Parte 1: Método de Detección. Organización Internacional de Normalización [ISO]: Geneva, Switzerland, 2018.
- UNE-EN ISO 9308-1:2014/A1; Recuento de Escherichia Coli y de Bacterias Coliformes Parte 1: Método de Filtración Por Membrana Para Aguas Con Bajo Contenido de Microbiota. Organización Internacional de Normalización [ISO]: Geneva, Switzerland, 2014.
- UNE-EN ISO 22717; Detección de Pseudomonas aeruginosa. Organización Internacional de Normalización [ISO]: Geneva, Switzerland, 2020.
- UNE-EN ISO 22964; Método Horizontal Para La Detección de Cronobacter spp. Organización Internacional de Normalización [ISO]: Geneva, Switzerland, 2017.
- UNE-EN 116005; Fabricación Por Adición de Capas En Materiales Plásticos. Organización Internacional de Normalización [ISO]: Geneva, Switzerland, 2012; pp. 1–10.
- Grande Burgos, M.J.; Fernández Márquez, M.L.; Pérez Pulido, R.; Gálvez, A.; Lucas López, R. International Journal of Food Microbiology Virulence Factors and Antimicrobial Resistance in Escherichia Coli Strains Isolated from Hen Egg Shells. Int. J. Food Microbiol. 2016, 238, 89–95. [Google Scholar] [CrossRef]
- López Aguayo, M.d.C.; Grande Burgos, M.J.; Pérez Pulido, R.; Gálvez, A.; Lucas López, R. Effect of Different Activated Coatings Containing Enterocin AS-48 against Listeria monocytogenes on Apple Cubes. Innov. Food Sci. Emerg. Technol. 2016, 35, 177–183. [Google Scholar] [CrossRef]
- Caballero Gómez, N.; Abriouel, H.; Grande, M.J.; Pérez Pulido, R.; Gálvez, A. Effect of Enterocin AS-48 in Combination with Biocides on Planktonic and Sessile Listeria monocytogenes. Food Microbiol. 2012, 30, 51–58. [Google Scholar] [CrossRef]
- Ortega Blázquez, I.; Grande Burgos, M.J.; Pérez-Pulido, R.; Gálvez, A.; Lucas, R. Inactivation of Listeria in Foods Packed in Films Activated with Enterocin AS-48 plus Thymol Singly or in Combination with High-Hydrostatic Pressure Treatment. Coatings 2017, 7, 20. [Google Scholar] [CrossRef]
- Martínez Viedma, P.; Grande Burgos, M.J.; Pérez Pulido, R.; Soriano, B.; Gálvez, A.; Lucas, R. Inhibition of Salmonella enterica and Listeria monocytogenes in Tofu by Activated Plastic Films. J. Food Prot. 2016, 2, 25–29. [Google Scholar]
- Oberdörster, G.; Oberdörster, E.; Oberdörster, J. Nanotoxicology: An Emerging Discipline Evolving from Studies of Ultrafine Particles. Environ. Health Perspect. 2005, 113, 823–839. [Google Scholar] [CrossRef] [PubMed]
- Mucha, M.; Bialas, S.; Kaczmarek, H. Effect of Nanosilver on the Photodegradation of Poly (Lactic Acid). J. Appl. Polym. Sci. 2014, 131, 40144. [Google Scholar] [CrossRef]
- Gan, L.; Geng, A.; Jin, L.; Zhong, Q.; Wang, L.; Xu, L.; Mei, C. Antibacterial Nanocomposite Based on Carbon Nanotubes–Silver Nanoparticles-Co-Doped Polylactic Acid. Polym. Bull. 2020, 77, 793–804. [Google Scholar] [CrossRef]
- Li, W.; Zhang, C.; Chi, H.; Li, L.; Lan, T.; Han, P.; Chen, H.; Qin, Y. Development of Antimicrobial Packaging Film Made from Poly(Lactic Acid) Incorporating Titanium Dioxide and Silver Nanoparticles. Molecules 2017, 22, 1170. [Google Scholar] [CrossRef] [PubMed]
- Feng, Q.L.; Wu, J.; Chen, G.Q.; Cui, F.Z.; Kim, T.N.; Kim, J.O. A Mechanistic Study of the Antibacterial Effect of Silver Ions on Escherichia coli and Staphylococcus aureus. J. Biomed. Mater. Res. 2000, 52, 662–668. [Google Scholar] [CrossRef]
- Gao, A.; Hang, R.; Huang, X.; Zhao, L.; Zhang, X.; Wang, L.; Tang, B.; Ma, S.; Chu, P.K. The Effects of Titania Nanotubes with Embedded Silver Oxide Nanoparticles on Bacteria and Osteoblasts. Biomaterials 2014, 35, 4223–4235. [Google Scholar] [CrossRef]
- Rohatgi, A.; Gupta, P. Infection, Genetics and Evolution Natural and Synthetic Plant Compounds as Anti-Biofilm Agents against Escherichia coli O157: H7 Biofilm. Infect. Genet. Evol. 2021, 95, 105055. [Google Scholar] [CrossRef]
- Liang, H.; de Haan, W.P.; Cerdà-Domènech, M.; Méndez, J.; Lucena, F.; García-Aljaro, C.; Sanchez-Vidal, A.; Ballesté, E. Detection of Faecal Bacteria and Antibiotic Resistance Genes in Biofilms Attached to Plastics from Human-Impacted Coastal Areas. Environ. Pollut. 2023, 319, 120983. [Google Scholar] [CrossRef]
- Neetoo, H.; Ye, M.; Chen, H.; Joerger, R.D.; Hicks, D.T.; Hoover, D.G. Use of Nisin-Coated Plastic Films to Control Listeria monocytogenes on Vacuum-Packaged Cold-Smoked Salmon. Int. J. Food Microbiol. 2008, 122, 8–15. [Google Scholar] [CrossRef]

| Parameter | Value |
|---|---|
| Layer height (mm) | 0.2 |
| Nozzle diameter (mm) | 0.4 |
| Wall thickness (mm) | 0.8 |
| Fill (%) | 100 |
| Top and bottom layer number (Nº) | 4 |
| Printing temperature (°C) | 215 |
| Bed temperature (°C) | 60 |
| Sample | Control | Additive R | Additive S | |||
|---|---|---|---|---|---|---|
| Bacteria/ Time (h) | Listeria monocytogenes (CFU/mL) | E. coli (CFU/mL) | Listeria monocytogenes (CFU/mL) | E. coli (CFU/mL) | Listeria monocytogenes (CFU/mL) | E. coli (CFU/mL) |
| 0 | 0 | |||||
| 24 | 0 | 0 | 0 | |||
| Bacteria/ Material | Listeria monocytogenes (mm) | E. coli (mm) |
|---|---|---|
| PLA/R1 | 6.0 | 12.0 |
| PLA/R2 | 9.0 | 15.0 |
| PLA/S1 | 5.0 | 10.0 |
| PLA/S2 | 8.0 | 14.0 |
Disclaimer/Publisher’s Note: The statements, opinions and data contained in all publications are solely those of the individual author(s) and contributor(s) and not of MDPI and/or the editor(s). MDPI and/or the editor(s) disclaim responsibility for any injury to people or property resulting from any ideas, methods, instructions or products referred to in the content. |
© 2023 by the authors. Licensee MDPI, Basel, Switzerland. This article is an open access article distributed under the terms and conditions of the Creative Commons Attribution (CC BY) license (https://creativecommons.org/licenses/by/4.0/).
Share and Cite
López-Camacho, A.; Magaña-García, D.; Grande, M.J.; Carazo-Álvarez, D.; La Rubia, M.D. Preliminary Study of the Bactericide Properties of Biodegradable Polymers (PLA) with Metal Additives for 3D Printing Applications. Bioengineering 2023, 10, 297. https://doi.org/10.3390/bioengineering10030297
López-Camacho A, Magaña-García D, Grande MJ, Carazo-Álvarez D, La Rubia MD. Preliminary Study of the Bactericide Properties of Biodegradable Polymers (PLA) with Metal Additives for 3D Printing Applications. Bioengineering. 2023; 10(3):297. https://doi.org/10.3390/bioengineering10030297
Chicago/Turabian StyleLópez-Camacho, Anyul, Dulce Magaña-García, María José Grande, Daniel Carazo-Álvarez, and M. Dolores La Rubia. 2023. "Preliminary Study of the Bactericide Properties of Biodegradable Polymers (PLA) with Metal Additives for 3D Printing Applications" Bioengineering 10, no. 3: 297. https://doi.org/10.3390/bioengineering10030297
APA StyleLópez-Camacho, A., Magaña-García, D., Grande, M. J., Carazo-Álvarez, D., & La Rubia, M. D. (2023). Preliminary Study of the Bactericide Properties of Biodegradable Polymers (PLA) with Metal Additives for 3D Printing Applications. Bioengineering, 10(3), 297. https://doi.org/10.3390/bioengineering10030297

